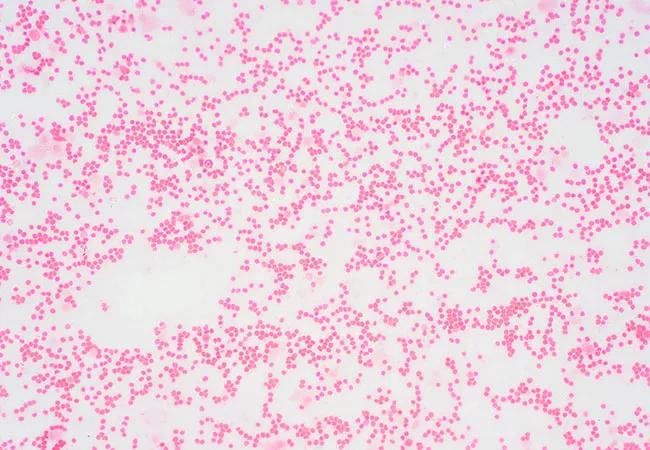

Momelotinib, a new JAK inhibitor, inches closer to market approval
Image content: This image is available to view online.
View image online (https://assets.clevelandclinic.org/transform/290362ec-f302-472b-8fda-434924a99bb9/22-CNR-2668718-CQD-Hero-650x450-1_jpg)
22-CNR-2668718-CQD-Hero-650×450-1
Momelotinib, an experimental JAK inhibitor for the treatment of myelofibrosis, appears to be highly effective for the treatment of anemia, one of the most difficult-to-treat manifestations of certain blood cancers. Findings from the ongoing MOMENTUM trial shed new light on how momelotinib can benefit patients with myelofibrosis.
Advertisement
Cleveland Clinic is a non-profit academic medical center. Advertising on our site helps support our mission. We do not endorse non-Cleveland Clinic products or services. Policy
“Results from MOMENTUM provide a promising path forward in the treatment of blood cancer-associated anemia – a complication for which other therapies have fallen short,” says Aaron Gerds, MD, an oncologist/hematologist in Cleveland Clinic’s Taussig Cancer Institute and one of several trial investigators.
Two earlier trials, SIMPLIFY-1 and SIMPLIFY-2, compared momelotinib to already approved myelofibrosis drugs, including ruxolitinib, but both studies had notable limitations. “These studies had no washout period and complex end points, so you really didn’t get a true sense of what a patient’s baseline symptoms were,” Dr. Gerds explains.
In myelofibrosis, abnormal bone marrow stem cells produce scar tissue that replaces healthy marrow cells. Ruxolitinib, a JAK inhibitor that is approved for the treatment of myelofibrosis and polycytheima vera, is effective for reducing certain symptoms, including increased spleen volume, fatigue, night sweats, fever, and itching. However, the drug has been inadequate for alleviating anemia, another common manifestation of myelofibrosis.
MOMENTUM aimed to achieve two main goals: 1) show that momelotinib can improve markers of anemia in patients with myelofibrosis, and 2) determine if the results, including improvements in symptom burden and spleen volume, were consistent with those of prior studies on the drug.
Despite how common anemia is in patients with myelofibrosis, Dr. Gerds notes that treating this complication poses a significant challenge for clinicians.
Advertisement
“Roughly 30% to 40% of myelofibrosis patients will be anemic at the time of diagnosis, and another 30% to 40% will become transfusion dependent over time,” he explains. “Currently available therapies can often worsen myelofibrosis-related anemia, so having a single agent that can address is really, really exciting.”
Myelofibrosis-associated anemia is not only very common, it is also associated with and inferior patient outcomes and worse quality of life and functional status. Patients often need to commit to weekly infusions that can, along with travel time, take up more than half of their day. “So anything that we can do to improve anemia in these patients will help improve their quality of life,” Dr. Gerds adds.
He further notes that blood is a valuable resource and that blood bank shortages across the country are not getting better.
“We need to become better stewards of our blood banks,” he emphasizes.
Lastly, anemia is associated with inferior outcomes in patients with myelofibrosis — both progression-free survival and overall survival. “The idea is that if we can make inroads on the anemia, perhaps we can reverse some of the negative associations we see with anemia in patients with myelofibrosis,” he says.
Momelotinib proved very effective in alleviating anemia in a significant group of patients with myelofibrosis. In fact, 31% of patients receiving a once-daily oral dose of the drug achieved transfusion independence, compared to only 13% who were transfusion independent at the beginning of the study. Furthermore, an additional 5% of patients who were previously treated with the steroid danazol achieved transfusion independence after being switched from danazol to momelotinib (an increase of 15%-20%).
Advertisement
“The topline results showed that, compared to danazol, there were significant numbers of patients that became transfusion independent and were, in time, freed of transfusion,” he says. “Likewise, the numbers of spleen volume responses as well symptom burden improvements were comparable to prior studies done on momelotinib.”
Researchers are in the process of gathering the latest results to present at upcoming medical conferences. Additional data is still needed before filing for FDA approval.
“This is just the first cut-off at the primary end point — week 24,” he says. “There are additional database locks that are occurring right now, and analysis of that data will serve as a key piece of the submission to regulatory authorities for approval.”
Dr. Gerds emphasizes that momelotinib has cleared a lot of experimental and administrative hurdles during development; it is now close to reaching the market thanks to a dedicated team of investigators.
“Our progress is really a testament to that community and its dedication and commitment to delivering new therapies for patients,” he concludes.
Advertisement
Advertisement
Best practices for supporting patients with honesty and compassion
Goal-of-care discussions drive earlier hospice access
Clinical trials and de-escalation strategies
Combination therapy improves outcomes, but lobular patients still do worse overall than ductal counterparts
Bringing empathy and evidence-based practice to addiction medicine
Supplemental screening for dense breasts
Combining advanced imaging with targeted therapy in prostate cancer and neuroendocrine tumors
Early results show strong clinical benefit rates